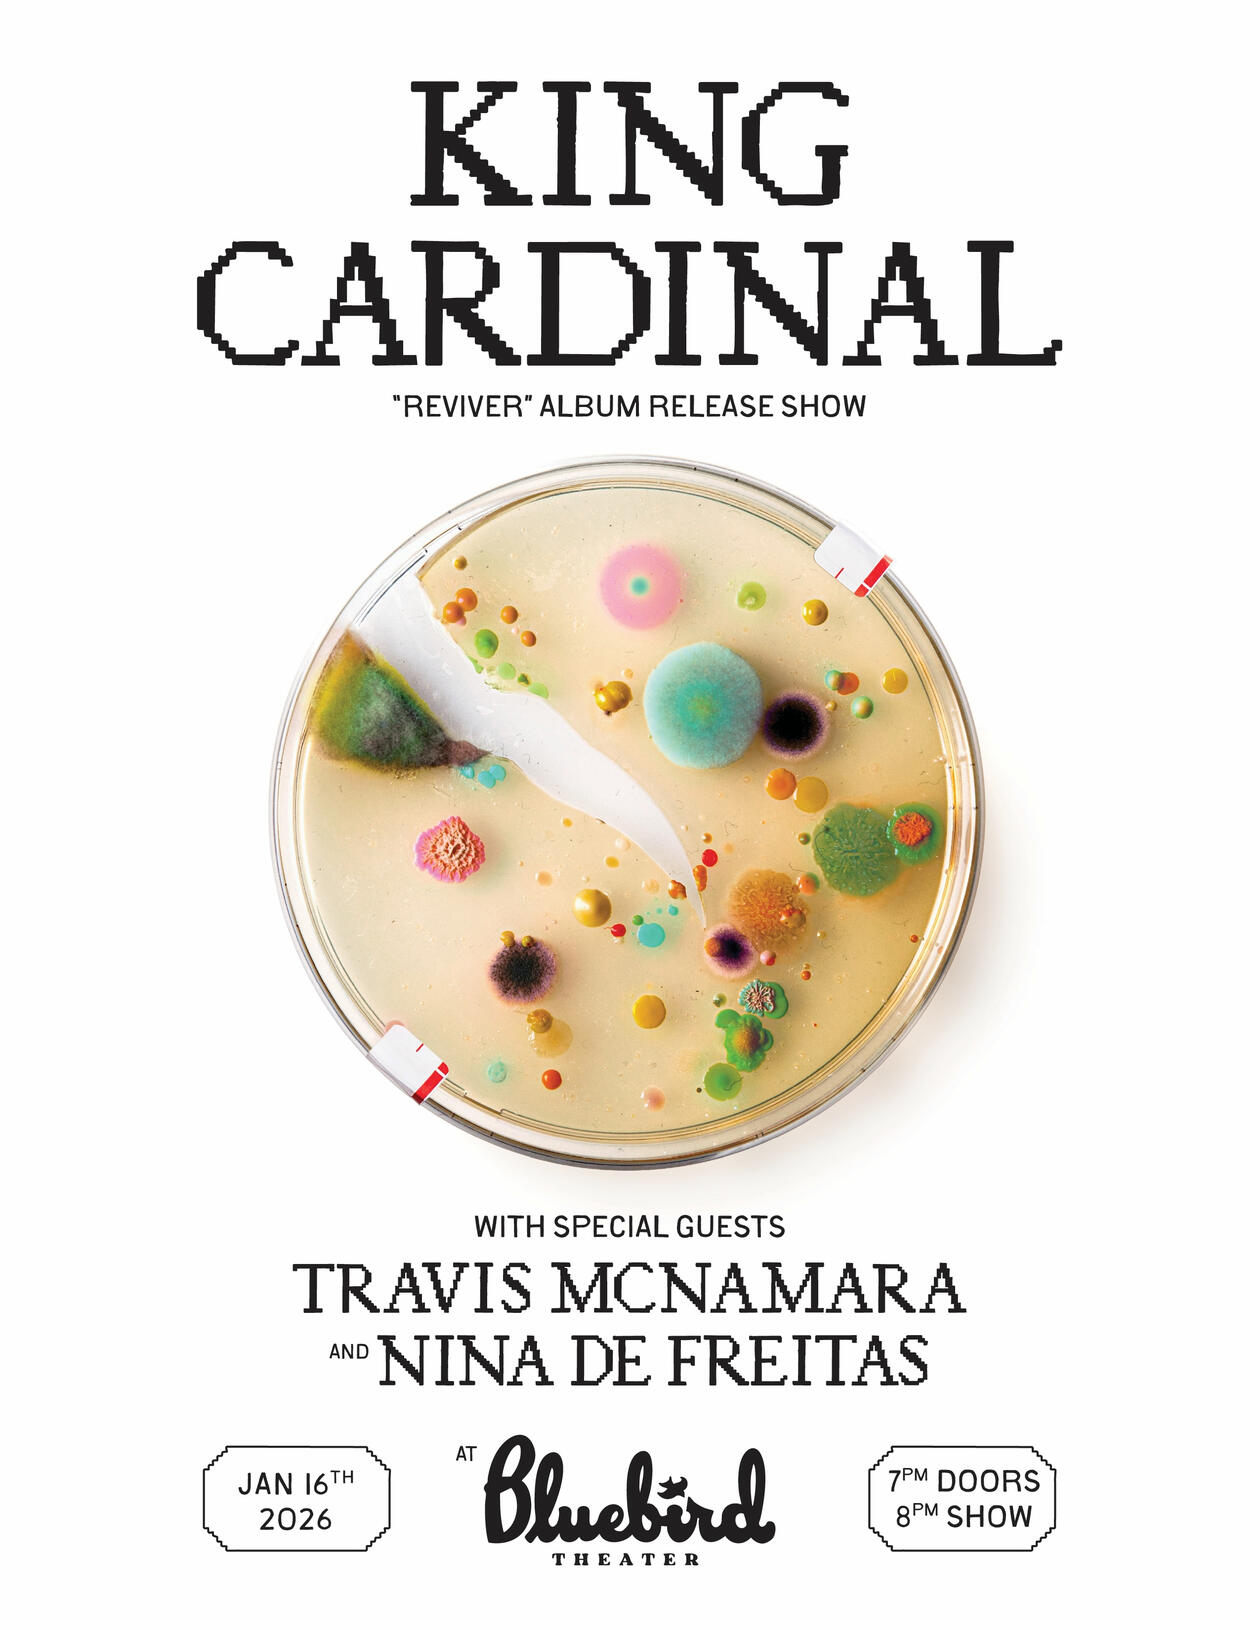

Fri Jan 16, 2026 - 8:00 PM
KING CARDINAL
"REVIVER" Album Release Show
w/ Travis McNamara and Nina de Freitas
Bluebird Theater, Denver, CO, United States | Ages: 16 & Over
KING CARDINAL
"REVIVER" Album Release Show
w/ Travis McNamara and Nina de Freitas
Bluebird Theater, Denver, CO, United States | Ages: 16 & Over